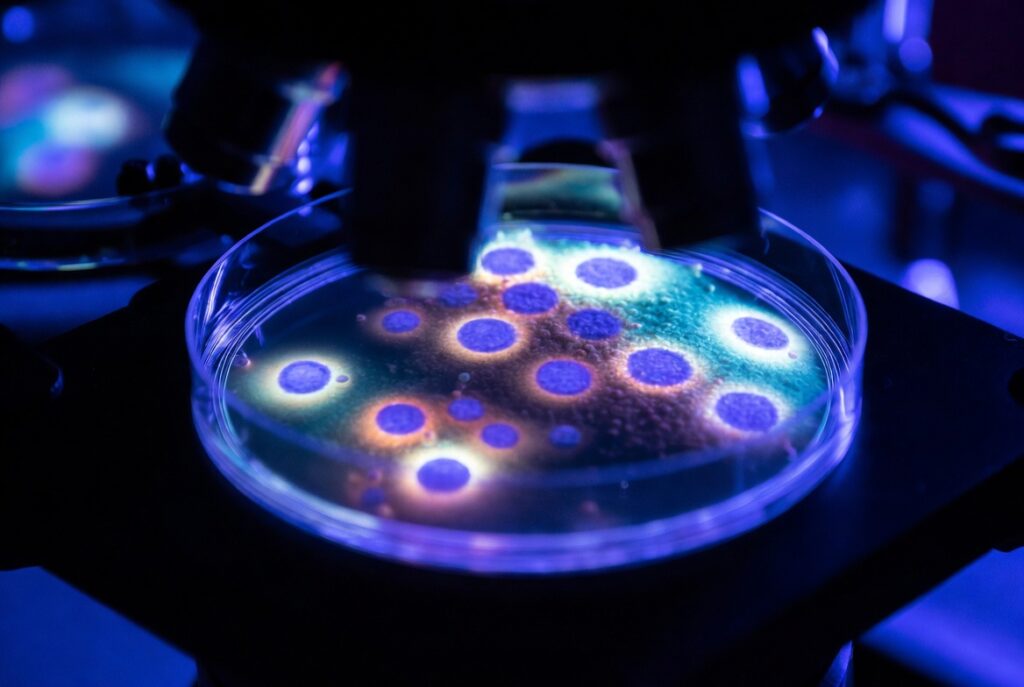

Today in Medmultilingua
On April 1, 2026, the Dutch expedition ship MV Hondius cast off from Ushuaia, Argentina — one of the southernmost ports on Earth — carrying 147 passengers of 23 nationalities on a voyage through the remote islands of the South Atlantic. By the time the vessel finally docked in Tenerife, Canary Islands, on the morning of May 10, it had become the unlikely stage for one of the most medically extraordinary events of the decade.
The culprit: Andes hantavirus, a pathogen born not in laboratories or crowded cities, but in the windswept grasslands and forests of Patagonia, carried silently in the lungs of small rodents. [Read more]